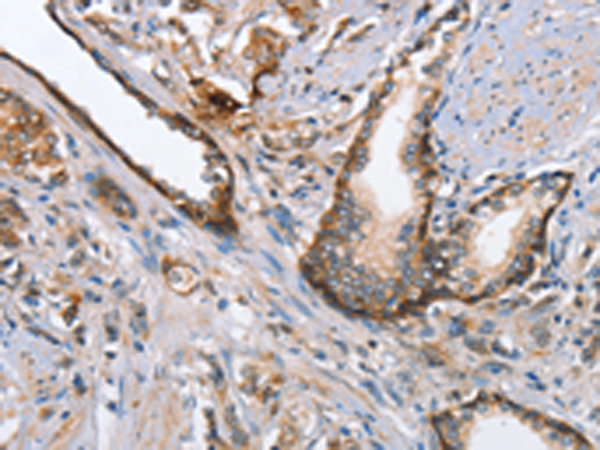

-
分类: 科研抗体货号: P07409别名: ARM1; EMSP; PSTS; AI2A1; EMSP1; KLK-L1; PRSS17; kallikrein应用: IHC反应种属: Human
-
分类: 科研抗体货号: P07408别名: hK1; KLKR; Klk6应用: IHC反应种属: Human
-
分类: 科研抗体货号: P07407别名: FLA10; KLP-20应用: WB,IHC反应种属: Human, Mouse
-
分类: 科研抗体货号: P07423别名: LRP, VAULT1应用: WB,IHC反应种属: Human, Mouse, Rat
-
分类: 科研抗体货号: P07431别名: CMT2; RP1-261G23.6应用: WB,IHC反应种属: Human
-
分类: 科研抗体货号: P07422别名: FPL; IDC; LFP; CDDC; EMD2; FPLD; HGPS; LDP1; LMN1; LMNC; MADA; PRO1; CDCD1; CMD1A; FPLD2; LMNL1; CMT2B1; LGMD1B应用: WB,IHC反应种属: Human, Mouse, Rat
-
分类: 科研抗体货号: P07430别名: MAD2; HSMAD2应用: WB,IHC反应种属: Human, Mouse
-
分类: 科研抗体货号: P07421别名: LMN; ADLD; LMN2; LMNB应用: WB,IHC反应种属: Human, Mouse, Rat
-
分类: 科研抗体货号: P07429别名: MAD1; PIG9; TP53I9; TXBP181应用: WB,IHC反应种属: Human, Mouse
-
分类: 科研抗体货号: P07420别名: GRH; GNRH; HH12; LHRH; LNRH应用: IHC反应种属: Human

鄂公网安备42018502007531号
鄂公网安备42018502007531号

